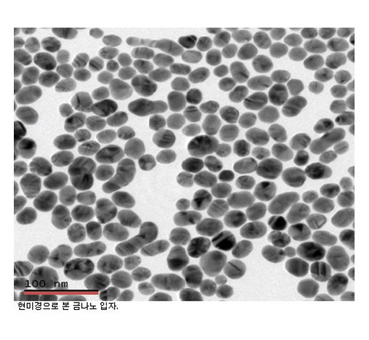

한국세라믹학회 2011년도 수석부회장 겸 차기회장 선출  지난달 16일 한국세라믹 학회 2011년도 수석부회장 겸 차기회장 선거에서 KAIST 강석중 교수가 선출됐다.
지난달 16일 한국세라믹 학회 2011년도 수석부회장 겸 차기회장 선거에서 KAIST 강석중 교수가 선출됐다.
강석중 교수는 서울대학교 공과대학 출신으로 재료계면공학연구센터 소장, 국가지정연구실 책임교수, 나노과학기술연구소 소장을 역임했으며 현 KAIST 신소재공학과 교수, 나노계면연구센터 소장을 맡고 있다.
한편 함께 투표한 2011년도 이사 및 감사 선거결과는 다음과 같다.(가나다순)
이사 13명: 강석중 김도경 김도연 김득중 김영욱 김해두 김형준 김호기 류한일 유광수 최덕균 하조웅 홍국선
감사 2명: 김응수 유상임
이번 투표는 8월 23일 ~ 9월10일(당일 도착 우편 분까지 유효)까지 우편발송으로 진행됐다.
파인세라믹스협회, 구조세라믹
산업 전문가 간담회 개최  한국파인세라믹스협회(회장 정무수/ 이하 협회)가 지난달 10일 강릉 KFCC에서 구조세라믹산업의 경쟁력 강화 및 상생협력 방안을 위한 전문가 간담회를 개최했다.
한국파인세라믹스협회(회장 정무수/ 이하 협회)가 지난달 10일 강릉 KFCC에서 구조세라믹산업의 경쟁력 강화 및 상생협력 방안을 위한 전문가 간담회를 개최했다.
이날 행사는 지식경제부 무역위원회의 위탁으로 구조세라믹 산업경쟁력조사를 수행중인 협회에서 관련 분야의 전문가들을 대상으로 경쟁력 강화방안에 대한 의견수렴을 위해 마련된 자리. 협회 유성근 전무는 “한국세라믹기술원, 재료연구소, 목포 JACC, 안동대 등이 참여한 전문가 그룹에서 수입의존형 구조세라믹스 국산화 지원사업 적극추진 등의 3대전략 9개방안으로 구성된 발전전략의 초안을 마련했다”며 이번 경쟁력조사를 통해 도출된 의견이 정책에 반영될 수 있도록 업계의 적극적인 동참을 주문했다.
다양한 의견들이 개진된 이날 간담회에서 한 중소기업 대표는 “리버스엔지니어링을 하다보니 스펙의 이유를 모른 채 제품을 만들고 있다”며 “모방이 아닌 혁신적인 제품개발을 위해서라도 대학과 출연연의 기초연구가 좀 더 활성화되어야 한다”는 자성어린 고백과 함께 기초연구에 대한 국가적 관심을 주문하기도 했다.
한편 이날 협회는 ‘파인세라믹산업 육성을 위한 중소기업 상생협력 방안’ 등 지식경제부와 대·중소기업협력재단과 함께 진행하고 있는 다양한 프로그램에 대한 소개. 특히 업종별 상생협력회의에 참여하고 있는 타 업종과의 합동행사를 통해 수요산업과의 상생협력방안을 강화할 방침임을 밝혔다.
써모텍,
LTCC용 원료분말 일본수출 쾌거  LTCC용 원료분말 및 장비업체인 써모텍(대표 김인태)이 일본시장 진출을 선언한지 3년 만에 난공불락의 빗장을 열고 초도물량 수출의 쾌거를 이룩했다.
LTCC용 원료분말 및 장비업체인 써모텍(대표 김인태)이 일본시장 진출을 선언한지 3년 만에 난공불락의 빗장을 열고 초도물량 수출의 쾌거를 이룩했다.
지난달 17일 강릉과학산업단지내 써모텍 공장에서는 신일본제철 계열사인 일철광업(日鐵鑛業)으로 수출될 LTCC원료의 출하식이 개최됐다. 이날 김인태 대표는 “지난 2007년 세라믹원료소재의 일본시장 개척을 위해 강릉TP 세라믹신소재산업 클러스터로 이전한지 3년만에 그 꿈을 이루게 됐다”며 “오늘 출하되는 물량은 소량에 불과하지만 그동안 도움을 주신분들게 일본에 첫 제품을 선적하는 날 모시겠다는 약속을 지키기 위해 마련된 자리로 마련됐다”고 설명한다.
이번에 1차로 출하된 물량은 모두 600kg이지만 일철광업측은 이 원료로 그린시트를 생산, 고객사의 성능 확인한 후 수입규모를 월 3톤 규모로 까지 확대할 방침으로 전해진다.
그동안 6차례의 까다로운 품질테스트를 통해 초도 물량을 납품하게 된 만큼 마지막 절차도 순조로운 진행이 기대되고 있다.
써모텍은 현재 일철광업 외에도 일본 굴지의 세라믹기업들과 협상을 진행중에 있으며, 이번 수출을 계기로 일본시장 공략이 한층 힘을 받게 될 전망이다.
BAU 2011 설명회 개최
독일뮌헨박람회 한국대표부 (주)케 틱은 지난달 1일 밀레니엄 서울 힐튼 호텔에서 뮌헨 신무역박람회센터에서 개최되는 BAU 2011의 설명회를 가졌다.
틱은 지난달 1일 밀레니엄 서울 힐튼 호텔에서 뮌헨 신무역박람회센터에서 개최되는 BAU 2011의 설명회를 가졌다.
BAU는 세계 40여 개국 1900여개의 전시업체가 참가하는 건축, 자재, 시스템 관련 세계 대표 박람회로 1960년대 처음 개최된 이래 2년에 한번 씩 독일에서 개최된다.
BAU 2011는 오는 2011년 1월 17일부터 22일까지 개최되며 약 150여 개국 21만 명 이상이 방문할 것으로 예상된다.
박람회 마다 매번 새로 정의되는 BAU의 핵심 테마는 이번 BAU 2011에서 지속가능성, 삶을 위한 건축, 연구와 혁신, 교육과 훈련이라는 네가지 테마로 정해져 건축의 미래를 지향하는 모습을 보여줄 예정이다.
한편 이번 박람회에선 타일과 세라믹 부문은 더욱 확대 되어 전시장 A6에서 내장 및 외장과 관련된 최신 아이디어와 제품들을 전시 하며, 이밖에도 신소재 인텔리전트 자재와 재료, 시스템 및 공정의 개발과 이용 방법 등을 선보일 예정이다.
지경부, 리튬 트라이앵글 추진 중  지난달 6일 지식경제부와 관련업계(광물자원공사, 포스코, LG상사, GS칼텍스, 대우인터내셔널 등) 등은 세계 리튬 매장량의 73.5%를 차지하는 ‘리튬 트라이앵글(볼리비아, 아르헨티나, 칠레)’개발 프로젝트 지분투자를 추진하고 있다고 밝혔다.
지난달 6일 지식경제부와 관련업계(광물자원공사, 포스코, LG상사, GS칼텍스, 대우인터내셔널 등) 등은 세계 리튬 매장량의 73.5%를 차지하는 ‘리튬 트라이앵글(볼리비아, 아르헨티나, 칠레)’개발 프로젝트 지분투자를 추진하고 있다고 밝혔다.
우리나라는 지난 8월 26일 단일지역으로는 세계 최대의 리튬 매장지인 볼리비아(우유니 소금호수)와 리튬 개발 및 산업화를 공동으로 진행하는 내용의 양해각서(MOU) 체결을 시작으로 리튬 확보전에 뛰어들었다. 볼리비아의 행정수도 라파스에서 남서쪽으로 200㎞ 떨어진 곳에 위치한 우유니 소금 호수는 경기도 면적보다 넓은 1만2000㎢ 크기의 호수에 540만t의 리튬이 매장되어 있다. 이는 세계 리튬 매장량의 47% 규모다.
이밖에도 현재 탐사단계인 338㎢ 규모의 아르헨티나 북부 옴브레 무에르토 염수호에는 42만5000t가량의 리튬이 매장돼 있는 것으로 추정되며, 앞으로 연 1만2000t가량의 탄산리튬과 4만9000t가량의 염화칼륨이 생산될 전망이다. 한국 업체 세 곳(광물자원공사, GS칼텍스, LG상사)은 각각 10%씩 총 30% 지분 확보를 추진 중이며, 모두 합쳐 1500만달러(170억원)가량의 투자금이 들어갈 전망이다.
광물자원공사는 또 세계 최대 리튬 매장국인 칠레의 아타카마 염수호 리튬 추출 사업에도 30%가량의 지분 참여를 추진 중이다. 이미 개발 준비단계에 들어선 이 광구에는 300만t가량의 리튬이 매장된 것으로 추정되며, 일단 연 2만t 규모의 탄산리튬 생산 설비를 갖춘 뒤 4만t 규모로 확장할 계획이다.
포스코켐텍,
이차전지 소재사업 진출
포스코켐텍은 지난 8월31일 포스코의 광양화성공장을 위탁 경영키로 했다고 공시했다. 내년 8월까지 1년간 위탁 경영을 하며 계약금액은 702억원 규모다. 또 포스코켐텍은 LS엠트론으로부터 이차전지음극재 자산을 35억1000만원에 양수키로 했다고 공시했다.
이번 위탁 운영으로 포스코켐텍은 2011년에 1200~1300억원 규모의 매출액 증가분을 반영하게 될 전망이다.
증권가에서는 포스코켐텍의 광양화성공장 위탁경영과 2차전지음극재 자산 양수도로 화학사업 진출이 가시화되고 있다며 긍정적인 평가를 내놨다.
젠한국,  오창공장 건설로 국내시장 공략
오창공장 건설로 국내시장 공략
도자기 생산업체 젠한국(대표 김성수)은 충북 오창에 본사 건물 및 공장을 신축 완공했다고 지난달 16일 밝혔다.
이 공장은 6794㎡ 부지에 창고동 4층과 본동 1층으로 구성되어 있으며, 본동 1층에는 도자기제품을 구입할 수 있도록 아울렛매장과 휴식을 취할 수 있는 공간을 만들었다. 기존 청주에 있던 연구·개발(R&D)센터도 신공장으로 옮겨 오는 11월부터 월 30만개의 도자기를 생산할 계획이다.
젠한국은 그동안 인도네시아에서 월 200만개 생산 규모의 공장을 운영해 왔다. 전체 물량의 80% 정도는 미국,유럽 등의 럭셔리 브랜드에 주문자상표부착생산(OEM) 방식으로 납품하고 20%만 국내로 들여와 자체 브랜드인 ‘ZEN’으로 판매했다.
SKC솔믹스,
사파이어 잉곳사업 진출
SKC솔믹스는 지난달 9일 이사회를 열어 부지매입에 78억 원을 투자하기로 결의하고, 경기 평택시 장당공단내 1만3223㎡의 LED용 사파이어 웨이퍼 사업 부지 매입계약을 체결했다고 밝혔다.
반도체 및 LCD용 구조세라믹에서 출발한 SKC솔믹스는 올해 말 태양전지용 실리콘 웨이퍼 60MW 양산라인을 구축하고, LED용 사파이어 잉곳 및 웨이퍼 등으로 사업영역을 확장해 나가고 있다.
주광일 SKC솔믹스 대표는 “국내 LED용 사파이어 웨이퍼의 수요는 매년 20%이상 급증하고 있으나 주요 핵심소재를 해외에 의존하고 있다”며 “SKC솔믹스가 보유하고 있는 실리콘 잉곳 성장기술 및 가공기술과 일본, 러시아 등의 선진기술을 도입해 경쟁력을 갖추겠다”고 말했다.
한편 SKC솔믹스의 모회사인 SKC는 태양전지용 폴리에스터(PET) 필름, 에틸비닐아세테이트(EVA) 시트 및 불소 필름을 모두 개발, 양산에 성공하면서 세계 최초로 태양전지용 필름을 모두 생산하는 기업으로 발전. 최근 충북 진천 공장에 1만8000톤 규모의 태양광 모듈용 EVA 시트 생산라인과 백 시트 생산설비를 건설 중에 있으며 태양광과 발광다이오드 등 무기소재 분야를 차세대 성장축으로 육성할 계획이다.
SKC와 SKC솔믹스는 그린에너지의 두 축인 태양전지와 LED의 주요 전·후방 소재를 중심으로 시너지 효과를 강화해 그린산업의 토털 솔루션을 제공한다는 계획이다.
대기업들
탄소소재 시장 줄줄이 진출
지난달 1일 롯데그룹 계열 석유화학사인 호남석유화학은 탄소복합재 기업인 데크항공의 주식 ‘50%+1주’와 경영권을 인수했고 밝혔다. 이번 인수를 계기로 호남석유화학은 지난해 인수한 장섬유복합재 생산기업 삼박엘에프티㈜, 2008년 인수한 친환경 발포PP생산회사인 하오기술㈜ 등을 통해 고기능성 소재 사업을 강화해 현재 전체 매출의 6%인 이 분야를 2018년 17%까지 끌어올려 포트폴리오를 다각화할 계획이다.
이밖에도 LG화학, GS칼텍스 등 주요 대기업들이 신사업인 탄소소재 시장에 잇따라 진출하고 있다.
LG화학은 지난 7월 세계시장 선점 10대 소재(WPM) 가운데 한 분야인 ‘에너지 절감, 변환용 다기능성 나노복합소재’ 분야의 총괄기업으로 선정돼 금속, 고분자, 세라믹 등의 탄소나노튜브, 그래핀 등을 분산시켜 기능을 강화하였으며, GS칼텍스는 신일본석유와 50대 50으로 투자해 설립한 파워카본테크놀로지를 통해 연간 300t 규모의 고출력 이차전지용 ELDC용 탄소소재를 양산해 IT와 접목된 탄소소재 시장으로 진출할 계획이다.
전북 탄소밸리 구축사업 관련기업속속들이 참여
전북도는 최근 탄소밸리 구축사업이 정부의 예비타당성 조사를 통과함에 따라 내년부터 오는 2015년까지 국비 1087억원을 포함해 총 1991억원을 투입해, 사업이 완료되는 2015년 이후에는 탄소산업 집적화를 위해 전주 친환경복합단지와 완주 테크노밸리를 탄소소재산업 특구로 지정할 계획이라 밝혔다.
국내 탄소소재 시장은 2008년 기준 1조4454억원 규모이지만 국내에서는 상용기술이 없어 전량 수입에 의존해 오고 있다. 탄소배출 저감이 자동차업계의 화두로 떠오르면서 수입규모가 오는 2015년에는 2조4000억원까지 치솟을 전망이다.
전북도는 전주기계탄소기술원과 한국과학기술연구원(KIST) 전북 분원을 중심으로 연구소와 기업을 집적, 고성능·초경량 복합소재 응용기술을 개발해 상용화에 주력할 방침이다. 이런 가운데 효성·한화나노텍·OCI·금호석유화학·한화나노텍 등 대기업을 비롯해 데크·나노솔루션·탑나노시스 등 관련 기업들이 전북 탄소밸리 구축사업에 속속 참여하고 있다.

전남에 기능성 소재 및
바이오 기업 잇따라 입주
최근 전남도 등 관련 기관은 현재 전남 장성 ·화순·나주 등지에는 생체재료·친환경 소재·신약물질 등 기능성 소재 및 바이오 관련 업체 10여 개 사가 자리 잡고 있으며, 내년까지 서울과 경기, 광주 등지에서 20여 기업이 추가로 입주할 예정이라 밝혔다.
대표 기업으로 단백질 펩타이드 전문 개발업체 애니젠은 전남 장성 나노바이오단지에 40억원을 투입해 생산라인을 구축했으며, 기능성 소개 전문업체 청화메디파워와 누리엠웰니스는 서울에서 장성으로 둥지를 옮겼다. 또 경기도에 있는 지앤지바이오메디컬은 전남 장성에 10억원을 투입해 본사를 이전한 뒤 스텐트 등을 생산하고 있다. 이들 기업 외에도 나노실리카 응용소재와 나노코팅, 바이오 필터 및 촉매 등을 개발하는 15개 업체가 전남 이전에 높은 관심을 보이고 있는 것으로 알려졌다. 이처럼 전남지역에 기능성 소재 및 바이오 업체들이 몰리고 있는 것은 전남지역이 전국 작물 생산량의 30%를 차지하고 있는데다, 전남나노바이오연구센터(장성), 생물의약연구센터(화순), 식품산업연구센터(나주), 전라남도천연자원연구원(장흥) 등 인프라가 비교적 잘 갖춰져 있기 때문이다.
전남도는 이러한 인프라를 바탕으로 수도권과 외지의 기능성 소재 및 바이오 기업이 입주해 본격 생산 활동에 들어가면 국내 최고의 집적화 단지로 자리매김할 수 있을 것으로 전망하고 기업 유치와 인프라 확충에 박차를 가하고 있다.
신성장 분야 수입원자재·부품 관세 인하 .jpg)
지난 8월 29일 지식경제부는 2차전지에 사용되는 황산코발트와 황산망간, LED에 쓰이는 다이아몬드코팅와이어, 태양전지와 풍력발전에 필요한 탄산이나트륨 등 20개의 신성장 분야 원자재와 부품 등 37개 품목에 대해 관세를 낮추는 안이 기획재정부의 ‘2010 세제개편안’에 포함됐다고 밝혔다.
황산코발트·타산망간 등은 2차전지용 원자재로 대부분을 수입해 사용한다. 이들 관세는 8%에서 5%로 낮아진다. 관세 인하 효과를 2009년 기준으로 적용하게 되면 국내 2차전지 업계에서만 20만달러 이상의 원재료 구입비 절감 효과를 낼 것으로 추정된다.
지경부는 이 같은 관세 인하로 국내 업체들의 경쟁력 강화에 도움이 될 것이며, 아직 초기인 신성장 산업 분야를 크게 확대할 것으로 기대했다. 개편안은 국회 통과 절차를 거쳐 이르면 내년 1월부터 적용될 예정이다.
서울메트로 신기술공법 특허권 획득
서울메트로(사장 김익환)는 최근 친환경 무기질 신소재와 이를 이용한 콘크리트 균열보수 및 차수그라우팅 신기술공법 특허권을 획득했다고 밝혔다.
이번에 획득한 특허는 콘크리트 구조물이 누수 혹은 균열로 보수가 필요할 시 친환경 신소재 광물이 혼합된 무기질 재료를 주입하여 구조물의 내구성을 향상시키는 공법이다.
기존 공법이 균열과 누수 시 주입물로 에폭시나 아크릴, 우레탄 등 화학물질을 사용한 반면 신공법은 친환경 맥반석을 사용하여 토양이나 지하수를 오염시키지 않는다는 장점이 있다. 또한 시공이 쉬우며 품질이 우수하고 원가도 1/3수준에 불과하다. 특히 기존의 에폭시 등과는 달리 맥반석은 콘크리트와 물리적인 성질이 유사하여 구조물의 내구성을 크게 증진시키고 유지관리가 쉽다.
이번 특허 획득으로 서울메트로는 기존 콘크리트 구조물의 유지·보수 작업을 더욱 효율적으로 진행할 수 있을 것으로 보고 있으며, 철도관련분야 뿐 아니라 다양한 분야에서 활용 가능해 기술사용료 수입도 기대하고 있다.
이그잭스, LED 방열부품 양산
이그잭스(대표 조근호)는 지난달 16일 서울 여의도에서 열린 기업설명회에서 LG이노텍 ·서울반도체·디에스LCD 등 LED 업체에 인쇄전자 기술로 제조된 방열부품 시제품을 공급했다고 밝혔다.
이 회사가 생산한 방열부품은 LED에서 발생할 열을 실시간으로 배출할 수 있도록 세라믹 코팅과 은(Ag) 인쇄 과정을 거친다. 열 전도율이 60W/m·K에 달해 기존 식각공정으로 제조된 방열부품(2W/m·K) 대비 30배나 빨리 열을 배출한다. 특수 프린터를 이용, 한 번에 인쇄하기 때문에 여러 번의 식각 공정을 거치는 것보다 제조원가가 저렴하다. 생산과정에서 폐수와 중금속을 배출하지 않아 친환경적이다. 이 회사는 경상북도 구미에 LED용 방열부품 생산라인 구축을 완료했으며 오는 4분기 양산을 앞두고 있다.
삼화콘덴서,
고출력 슈퍼커패시터 개발  지난달 15일 삼화콘덴서(대표 황호진)는 스마트그리드용 고출력(High Power) 슈퍼커패시터(Super Capacitor) 개발에 성공했다고 밝혔다. 슈퍼커패시터는 커패시터의 성능 중 특히 전기용량의 성능을 중점적으로 강화한 제품으로 충전지와 같은 기능을 갖는다.
지난달 15일 삼화콘덴서(대표 황호진)는 스마트그리드용 고출력(High Power) 슈퍼커패시터(Super Capacitor) 개발에 성공했다고 밝혔다. 슈퍼커패시터는 커패시터의 성능 중 특히 전기용량의 성능을 중점적으로 강화한 제품으로 충전지와 같은 기능을 갖는다.
삼화콘덴서의 슈퍼커패시터는 기존 제품 대비 등가직렬저항(ESR)이 30% 감소해 고출력이 가능하며 용량변화율이 낮아 제품수명이 20% 증가, 높은 신뢰성을 가지는 장점이 있다. 또한 졸겔(Sol-Gel)법을 새로 적용해 제조단가가 매우 낮다는 특징도 있다. 기존 슈퍼커패시터의 경우 활성탄(Active Carbon) 기반으로 이루어졌으나, 이번 신제품은 에어로젤탄소(Aerogel Carbon) 기반으로 개발됐으며 이러한 탄소소재는 향후 슈퍼커패시터의 소재뿐만 아니라 이차전지용 음극소재로도 적용이 가능할 전망이다.
삼화콘덴서의 스마트그리드용 고출력 슈퍼커패시터는 올해 약 1500억원 규모이나 2012년에는 1조원 가량으로 그 규모가 확대될 것으로 보인다.
‘이달의 과학기술자상’
이현우 교수 선정 
메타바이오메드는 천연산호를 이용한 골수복재 제조기술의 신기술 인증을 획득한다고 지난달 26일 밝혔다.
이번 인증은 천연 산호를 이용해 제조한 수산화인회석(Hydrox
yapatite)로 인간의 해면골 구조와 가장 유사한 기공구조를 가져 최적의 골 형성 환경을 제공하고 합성골로 인한 감염반응과 면역거부반응을 최소화 시켜주는 기술이다.
메타바이오메드는 지난해 신성장 동력사업의 일환으로 골수복재 분야에 본격 진출했다.
황민하 메타바이오메드 대표이사는 “다양한 원천기술 확보와 신제품 개발을 통해 골수복재 사업을 회사의 핵심성장동력으로 키워나갈 것이며, 이를 통해 새로운 매출기반을 확보해 나갈 것”이라고 전했다.
한나라 ‘과학기술특별위원회’
신설, 첫 위원장에 서상기 의원 지난달 13일 한나라당은 국내 과학기술정책 지원을 위해 당내 과학기술특위를 신설하고 특위 위원장에 서상기 의원(대구 북을)을 선임했다고 안영환 한나라당 대변인을 통해 전했다.
지난달 13일 한나라당은 국내 과학기술정책 지원을 위해 당내 과학기술특위를 신설하고 특위 위원장에 서상기 의원(대구 북을)을 선임했다고 안영환 한나라당 대변인을 통해 전했다.
이날 발표에 따르면 과학기술특별위원회는 앞으로 정부 정책을 지원하고 당내 정책을 개발을 추진하는 역할을 할 것이다.
한편 첫 위원장으로 뽑힌 서상기 의원은 1946년 대구 출생으로 경북중·경기고를 거쳐 서울대 재료공학과를 졸업했다. 이후 미국 웨인주립대학교대학원에서 석사학위를, 드렉셀대학교대학원에서 박사학위를 각각 취득했다. 정치 입문 전엔 미국 포드자동차 선임연구원·한국기계연구원 원장·호서대학교 환경안전공학부 교수를 거쳤으며, 2004년 총선에서 한나라당 후보로 당선돼 여의도에 입성하였다.
국과위 장관급 행정위원회로 격상
동아일보에 따르면 지난달 10일 정부와 한나라당은 대통령 직속 심의기구인 국가과학기술위원회(국과위)를 국가 연구개발(R&D) 예산의 편성 배분 조정권을 갖는 장관급 행정위원회로 격상시키기로 확정했다. 이로서 국과위는 방송통신위원회 공정거래위원회와 같은 위상을 갖고 연간 14조 원의 예산을 관리하게 된다.
2008년도 교육부와 과기부의 통합은 부총리급 정부조직을 축소하고 교육과 과학의 시너지 효과를 창출한다는 명분이었지만 이미 실패로 결론이 났다.
교과부로 통합되면서 조직 전체가 ‘사교육과의 전쟁’처럼 민감한 교육현안에 매달리느라 과학기술의 중장기적 주요 과제들은 뒷전으로 밀리거나 국민의 눈에 보이지 않았다. 과학기술이 교과부의 정책에서 소외되고 있다는 인식이 확산되면서 연구 인력의 사기도 크게 떨어졌다. 스위스 국제경영개발원(IMD)의 국가경쟁력 평가에서 한국의 기술 인프라 경쟁력은 2007년 6위에서 통합 1년째인 2009년 14위로 떨어졌다.
국과위를 발족한다지만 이미 교과부가 있는 상태에서 옥상옥(屋上屋)이 될 것이란 비판도 있다. 정부는 위원회를 발족하는 방안과 과거처럼 과기부를 두는 방식의 장단점을 면밀히 검토할 필요도 있다. 위원회로 가더라도 교육부 안에 있는 과기부 관련 실국을 모두 가져가 명실상부한 과학기술 행정을 집행토록 하는 것이 현명한 선택이다.
포스코-LS니꼬,
해외자원개발 MOU교환 국내 최대 철강사인 포스코와 대표적인 비철금속 LS니꼬동제련은 지난달 10일 삼성동 아셈타워에 위치한 LS니꼬 대회의실에서 해외자원 개발을 위해 전략적 제휴 MOU를 교환했다.
국내 최대 철강사인 포스코와 대표적인 비철금속 LS니꼬동제련은 지난달 10일 삼성동 아셈타워에 위치한 LS니꼬 대회의실에서 해외자원 개발을 위해 전략적 제휴 MOU를 교환했다.
이날 교환한 MOU에는 ▲해외광산개발 분야▲리싸이클링사업 분야▲부산물 활용 분야▲비철제련 분야 총 4개의 사업분야에 관한 내용이 적혀있다.
이번 협약은 전세계적으로 급변하는 경영환경 속에서 세계 최고 수준의 기술력을 가진 양사가 해외와 국내에서 협력해 기업은 물론, 국가산업발전에 기여하자는 취지에서 기획됐다.
현재 세계 지하자원개발산업에 선진국은 물론이고, 중국, 인도 등 신흥 공업국까지 끼어들어 자원확보경쟁이 가열되는 상황에서 이번 MOU는 자원확보경쟁력을 강화하는 데 큰 도움이 될 것으로 보이며, 다양한 기능성 신소재와 합금금속의 원료인 희속금속의 가치가 지속적으로 증가하고 있는 상황에서 철강과 동제련산업에서 최고의 기술력을 보유한 양사가 비철제련사업에 진출할 경우 막강한 경쟁력을 확보할 것으로 보인다.
국내 최초 한국형 인공무릎관절 개발 성공, 식약청 허가 취득
지난달 13일 코리아본뱅크(대표 심영복)는 국내 최초로 한국형 인공무릎관절(B-P Knee System) 개발에 성공해 식약청으로부터 제조품목허가(허가번호:제허 10-916호)를 취득했다고 밝혔다.
2009년 코리아본뱅크가 인수한 미국의 인공관절 전문회사인 엔도텍(Endotec Inc)의 선진 설계 및 가공기술력을 그대로 재현한 하여 세계 최초로 인체에 무해한 티타늄과 세라믹 코팅 기술이 적용 됐으며, 현재 미국 FDA에 등록 돼 있다.
이번에 개발된 제품은 현재 최대 시장점유율을 가진 다국적 의료기기 회사들의 코발트크롬 소재보다 중금속 소재에 대한 유해성 논란 차단, 3분1에 불과한 무게감, 3배 이상의 내구성 강화, 부작용 최소화 등의 다양한 효과가 예상된다. 또 좌우 45도 각도의 회전이 가능해 좌식생활에 익숙한 동양인 환자에게 최적화 되도록 제작된 점도 큰 장점이다.
코리아본뱅크는 예상보다 제품의 허가 취득이 빨라져 4분기부터는 서울 가산동 자체 생산시설에서 제품 양산을 통해 본격적인 국내 판매가 이뤄질 것으로 보았다.
LGD, 2012년부터 TFT 기판에
롤 프린팅 적용
정인재 LG디스플레이 부사장은 지난달 9일 전북 무주리조트에서 열린 ‘국제 인쇄전자 및 플렉시블 디스플레이 워크숍’에서 LG디스플레이가 이르면 2012년부터 롤 프린팅 공법을 대형 LCD 박막트랜지스터(TFT) 기판에 적용할 것이라고 발표했다.
기존 포토리소그래피 공정 대신 롤 프린팅 공법을 적용하면 각 포토리소그래피 공정의 감광물질 코팅, 노광, 현상 공정을 신문을 인쇄하듯 롤러를 이용해 한 번에 처리할 수 있다. LCD 장비나 재료 원가를 최고 30% 가까이 줄일 수 있는데다가 생산 시간도 줄어드는 등 제조 원가 경쟁에서 앞서갈 수 있다.
LG디스플레이는 이 같은 기술 개발을 위해 구미에 5세대(1000×1200㎜) 롤 프린팅 장비를 구축하고 연구개발을 진행해 왔다. 특히 지난해 컬러필터와 올해 블랙 매트릭스까지 롤 프린팅 양산 기술을 확보한 데 이어 이번 기술까지 확보함으로써 롤 프린팅 전 공정 양산 적용을 위한 기반 기술을 확보한 것으로 보인다.
업계 한 관계자는 “LG디스플레이가 확보한 TFT 롤 프린팅 기술은 전 세계 LCD업체 중에서 가장 앞선 수준으로 평가된다”말했다.
한편 정 부사장은 내년부터 플라스틱 기판에 프린팅 공법을 이용한 플렉시블 디스플레이 개발에도 본격 나설 계획이라고 밝혔다. 플렉시블 디스플레이 연구개발은 전자종이(EPD)와 유기발광다이오드(OLED) 및 LCD를 망라해 병행 개발한다는 전략이다.
시스템 반도체산업 5년간 집중 육성  지식경제부는 시스템 반도체 및 장비산업 육성에 정부 예산 5000억 원을 포함해 민·관 합동으로 모두 1조 7000억 원을 투자할 계획이라고 지난달 9일 위기관리대책회의에서 밝혔다. 시스템반도체는 스마트폰 등에 들어가는 정보기술(IT)기기의 핵심 부품으로 IT기기의 ‘뇌’로도 불린다. 한국은 메모리반도체(데이터 저장용) 분야에서는 세계 시장 점유율 50%로 세계 1위지만 시스템반도체 분야 점유율은 3%에 불과하다.
지식경제부는 시스템 반도체 및 장비산업 육성에 정부 예산 5000억 원을 포함해 민·관 합동으로 모두 1조 7000억 원을 투자할 계획이라고 지난달 9일 위기관리대책회의에서 밝혔다. 시스템반도체는 스마트폰 등에 들어가는 정보기술(IT)기기의 핵심 부품으로 IT기기의 ‘뇌’로도 불린다. 한국은 메모리반도체(데이터 저장용) 분야에서는 세계 시장 점유율 50%로 세계 1위지만 시스템반도체 분야 점유율은 3%에 불과하다.
지경부는 “시스템반도체는 메모리반도체보다 시장 규모가 4배나 크고 매년 15%가 넘는 성장이 기대되는 유망 시장이지만 그간 대부분의 시장을 미국 인텔, 퀄컴사 등이 장악하고 있어 우리 기업의 진입은 소극적이었다”고 전했다. 지경부는 최고의 시스템반도체를 만들기 위해 2015년까지 세계적 수준의 ‘스타 팹리스’ 10개사를 육성할 방침이다.
신소재 그래핀 고자기장,
극초저온 현상 측정
지난달 9일 서울대(총장 오연천)에 따르면 서울대 물리천문학부 국 양 교수팀은 미국 표준기술연구원과 공동연구를 통해 그래핀의 전자구조를 명쾌하게 밝혀 그래핀을 이용해 열 손실이 적은 초소형ㆍ초고속 소자의 제작이 가능하다는 점을 물리적으로 증명했다.
연구진은 이번 관측으로 그래핀의 전자가 질량이 없는 상대론적인 운동을 하고 에너지에 무관하게 속력이 같다는 기존 이론이 정확함을 증명, 소자 설계 등에 응용할 수 있는 가능성을 제시했다.
지금까지 이론 물리학자들은 그래핀의 전자 구조는 아주 특이한 현상을 갖는다고 예측했고 이를 정확하게 이해하기 위해서는 고자기장, 극초저온에서 측정할 필요성이 제기돼왔다. 이에 미국표준기술연구원은 세계에서 가장 온도가 낮은 절대온도 0.01도, 지구 자기장의 30만배인 15테슬라에서 작동하는 초고진공주사형터널링현미경을 작년 초 설계 제작 후 완성, 이번 연구성과로 이어지게 됐다.
지난 47년 게르마늄을 이용한 트랜지스터가 발명된 후, 실리콘 소자의 집적화로, 전자소자의 고성능화를 이루고 전자시대를 가져왔다. 하지만 앞으로는 그래핀이 초고속 소자, 다기능 소자, 센서, 투명 전극으로 응용될 것이 예측된다고 연구진은 전했다.
2010 대덕특구 첨단기술제품
전시회 개막
‘2010 대덕특구 첨단기술제품 전시회’가 과천정부청사 후생동 지하 1층에서 지난달 9일 열렸다.
이틀 동안 열리는 전시회에는 그동안 대덕특구의 성과와 골프존의 골프 시뮬레이터, 디앤티의 LCD 모니터, 트루윈의 자동차 센서, 하기소닉의 초음파 센서, 케이맥의 박막 두께 측정기, 바이오니아의 합성유전자, 파워이십일의 조류 계산 프로그램 등 대덕특구에서 성장한 벤처기업 20개사의 다양한 첨단 제품과 신기술 아이디어 상품을 전시했다.
이번 전시회에는 대덕특구관 2개 부스와 첨단벤처관 21개 부스가 각각 운영되며 ‘대덕벤처 재도약 간담회’가 열린다. 또 대덕이노폴리스벤처협회와 인천벤처기업협회, 경기벤처기업협회가 상생협력 양해각서(MOU)를 체결하고 관련 세미나도 진행되었다.
한편 대덕특구에는 현재 정부출연연구기관을 비롯해 대학, 기업연구소의 연구 성과물 등을 기반으로 980개의 중소·벤처기업이 육성되고 있다. 이 가운데 골프존, 실리콘웍스 등은 매출 1000억원의 벤처 신화를 이뤘으며 17개 기업이 코스닥에 상장됐다.
저비용 신개념 광학적·전기적 소자, 신소재 권위지 표지 논문 채택  지난달 8일 서울대 전기컴퓨터공학부 이신두교수 연구팀은 나노입자들을 다양한 네트워크 구조로 배열시켜 신 개념의 광학적·전기적 소자를 저렴한 비용으로 생산할 수 있는 기술을 개발했다고 밝혔다.
지난달 8일 서울대 전기컴퓨터공학부 이신두교수 연구팀은 나노입자들을 다양한 네트워크 구조로 배열시켜 신 개념의 광학적·전기적 소자를 저렴한 비용으로 생산할 수 있는 기술을 개발했다고 밝혔다.
나노입자는 종류와 배열방식에 따라 다양한 기능을 갖는데, 특히 일렬로 연결된 나노입자선은 빛과 전자의 이동 통로가 될 수 있어 응용분야가 많다. 이 교수 연구팀은 기존 나노 리소그래피 공정 대신, 형판에 공기 방울 공간을 미세 패턴으로 만들어 그 주변의 계면이 다단계로 수렴하는 현상을 발견해 새로운 제조 공정을 개발해냈다.
이 연구 결과는 신소재·재료 분야의 세계적인 권위지인 ‘어드밴스트 머티리얼스’지의 표지 논문으로 채택돼 10월 1일자 인쇄판에 게재되었다.
한-미연구팀, 사파이어 기판 대체
기술 세계 첫 개발 성공 
한국광기술원(KOPTI·김선호) LED소자기술센터(센터장 백종협) 연구팀은 6인치 크기의 실리콘 웨이퍼 위에 질화갈륨(GaN) 층을 성장, LED를 생산하는데 성공했다고 지난 8월 30일 밝혔다. 이번 기술은 미국 유기금속화학증착장비(MOCVD) 업체 `비코`사와 공동 개발한 것으로 기존에 사용되던 고가의 사파이어 웨이퍼를 대체할 수 있는 것으로 평가받고 있다. 최근 독일·영국의 실험실 등에서 6인치 실리콘 웨이퍼 위에 GaN 층을 성장시키는 데 성공한 적은 있으나 상용장비를 이용해 제조에 성공하기는 이번이 세계 최초다.
연구팀에 따르면 현재 전 세계 질화갈륨 LED의 90%는 사파이어 웨이퍼를 사용하고 있으며 최근 LED 수요 급증으로 대량생산 체제에 돌입하면서 생산성 개선을 위한 LED용 사파이어 웨이퍼의 대구경화 경쟁이 치열하게 전개되고 있다. 그러나 기술의 어려움으로 소수의 기업만이 6인치급 이상의 사파이어 웨이퍼용 잉곳을 고가에 공급하고 있다. 반면에 실리콘 기판은 대구경으로 가격과 품질 측면에서 사파이어 웨이퍼에 비해 뛰어난 경쟁력이 있으며 전기 전도성과 방열 특성이 좋은데다 칩 가공이 쉽다는 장점을 갖고 있다. 하지만 사파이어 웨이퍼에 비해 실리콘 웨이퍼는 가시광선에 불투명해 광 손실이 크고 GaN과의 열팽창계수차가 커 불량이 발생하는 등 제조가 어렵다는 단점을 가지고 있었으나 이번에 한국광기술원 연구팀은 이러한 문제점을 해결했다.
연구팀은 지난 2004년부터 2008년까지 지식경제부 지역중점기술개발 사업을 통해 외부양자효율 15%의 2인치 실리콘 웨이퍼를 이용해 LED를 생산하는 데 성공한 바 있다. 이러한 결과를 바탕으로 미국 비코의 6인치급 상용 MOCVD를 이용, 6인치 실리콘 웨이퍼 위에 GaN 층을 형성하는 데 성공했다.
연구팀은 기술 난이도가 낮은 전자소자 시장에서는 이미 실리콘 기판이 사파이어 기판을 대체하는 추세로 미뤄볼 때 향후 실리콘 기판분리 공정 최적화 등 에피 공정 효율 개선이 이뤄질 경우 사파이어를 전량 대체할 수 있는 경제적 파급효과를 기대하고 있다.
일진반도체 일본Koyo와 손잡고 송도에 대규모 LED공장 건립
인천경제자유구역청은 발광다이오드(LED) 전문 생산업체인 일진반도체(주)와 ‘송도국제도시내 LED 제조시설 건립’을 내용으로 하는 투자계약을 체결했다고 지난달 9일 밝혔다.
일진반도체는 일본의 Koyo 그룹으로부터 50억원 상당의 투자를 받아 송도국제도시 지식정보산업단지 내 8362.8㎡(약 2500평)에 총사업비 180억원 규모로 올해 말까지 제조시설을 건립할 예정이다.
일본의 Koyo 그룹은 일본내 금융업 및 LED 제품 유통업을 전문으로 하고 있는 기업으로 최근 신규사업으로 친환경 녹색 성장 산업 진출을 희망하며 LED 투자를 결정했다. 일본의 Koyo그룹은 일진과 이미 구매계약을 체결하고 일본 내 확보하고 있는 다양한 유통망을 통해 LED 제품을 공급할 예정이다.
인천경제청 관계자는 “이번 투자계약으로 지역경제 활성화, 고용창출, 그린 에너지 대표 산업인 LED 관련 클러스터 구축에 박차를 가할 수 있을 것으로 기대된다”고 말했다.
KAIST연구팀, 고분해능
나노패턴 대면적 제작기술 개발
KAIST 정희태 교수 연구팀은 교육과학기술부와 한국연구재단의 ‘세계수준의 연구중심대학(WCU) 육성사업’의 ‘중견연구자지원사업 도약연구’의 지원을 받아 복잡하고 다양한 10nm대의 고분해능 나노패턴을 대면적에 효율적으로 제작할 수 있는 기술을 개발해 냈다고 지난달 8일 밝혔다.
이 기술은 차세대 반도체, 디스플레이 및 나노전자 소자개발에 핵심기술인 10nm급 패턴을 제작할 수 있는 신기술로 거의 모든 금속(금, 은, 알루미륨, 크롬)과 무기물(ZnO, ITO, SiO2)에 적용가능하며, 기존의 패터닝 방법과 비교해 낮은 공정비용과 간단한 실험공정으로 고해상도 패턴을 대면적에 균일하게 제작할 수 있다.
연구진은 전압차를 이용해 아르곤(Ar) 입자를 가속시켜 원하는 목적층에 물리적 충격을 주는 방법으로 선이나 컵 모양, 가운데가 비어있는 실린더(Hole-cylinder) 모양, 삼각 터널(triangle tunnel) 등 다양한 모양의 패턴을 제작했다. 이렇게 제작된 패턴은 웨이퍼, 유리기판, 쿼츠(Quartz), 금속판 뿐만 아니라 PET필름과 같은 플렉서블 기판에서도 공정이 가능하기 때문에 범용적으로 사용할 수 있다는 것이 연구진의 설명이다.
연구진은 투명한 쿼츠셀 위에 금 선 패턴을 제작하여 ITO기판을 대체할 수 있을 만큼 높은 성능을 갖는 투명전극을 제작해 태양전지에 응용함으로써 다양한 광학·전기적 나노소자에 응용할 수 있음을 보여줬다.
나노팹센터, 삼중접합 고효율 화합물반도체 태양전지 개발
나노소자특화팹센터(나노팹센터)는 지난달 7일 국내 최고 효율을 가진 화합물 반도체 태양전지를 개발했다.
나노팹센터가 개발한 태양전지는 InGaP(인듐-갈륨-인 화합물)과 GaAs(갈륨-비소 화합물), Ge(게르마늄) 태양전지를 이용한 삼중접합 구조의 ‘집광형 고효율 화합물반도체 태양전지’로, 빛을 전기로 변환하는 광전변환 효율이 28.60%에 달한다.
일반적으로 집광형 고효율 화합물반도체 태양전지는 이중접합 또는 삼중접합 구조이며, 나노팹센터는 지난해까지 화합물반도체인 InGaP(인듐-갈륨-인 화합물)과 GaAs(갈륨-비소 화합물) 이중접합 구조의 태양전지를 개발해 왔다. 이 과정에서 나노팹센터는 이중접합 광전변환 효율 최고기록(미국 NREL 연구소의 30.2%)에 근접하는 26.6%의 효율을 달성한 바 있다. 이번에 발표한 삼중접합 태양전지 효율은 집광전 측정 결과이며, 올해 집광이 가능한 전극 설계를 개발하여 삼중접합에서 집광 효율 35% 이상 달성을 목표로 하고 있다.
집광형 화합물반도체 태양전지를 이용한 태양광 발전 시스템은 초기 투자비용이 상대적으로 높은 반면 태양전지 효율이 35% 이상의 고효율이어서 소요 대지 면적이 작고 투자 회수기간이 짧아 우리나라와 같이 토지 비용이 높은 국가에 유리한 점이 있다.
센터는 고가의 화합물반도체 웨이퍼를 대체할 차세대 기술인 ‘실리콘 기판 이용 화합물반도체 에피 성장 기술’을 개발하여 저가격 고효율 태양전지 발전 시스템에 필요한 원천기술개발에도 역량을 기울일 계획이다.
태양전지용 폴리실리콘 공급난,
시장 점유율 확대할 좋은 기회
최근 전자신문에 따르면 지난해 7기가와트(GW)에 그쳤던 글로벌 태양광 시장이 독일과 이탈리아, 미국 등의 수요 증가로 올해 13GW 이상으로 확대되면서 연초 공급과잉 우려와 달리 폴리실리콘 공급난이 재연되고 있다고 한다.
태양광 시장 호황과 더불어 고순도 폴리실리콘의 수요증가로 인해 폴리실리콘 공급부족 현상을 보이고 있다. 고순도 폴리실리콘은 고효율 태양전지를 만드는 데 없어서는 안 될 소재다. 실제로 저순도를 포함하면 올해 폴리실리콘 시장은 7%가 넘는 공급과잉 상황이지만, 나인나인(99.9999999%)급 이상 고순도 폴리실리콘은 공급량이 14%가량 부족하다.
여기에 세계 10위권 생산 업체인 중국 LDK의 폴리실리콘 공장이 최근 화재로 생산을 중단했고, 5위권 기업인 노르웨이 REC도 수율 문제로 신규 생산에 차질을 빚고 있어 고순도 제품 공급난에 부채질을 하고 있다. 또한 텐나인급 최고 순도 폴리실리콘을 생산할 수 있는 기업은 전 세계에 6~8개 정도 뿐이어서 이와 같은 상황은 고순도 재품을 생산하고 있는 국내 폴리실리콘 업계에는 긍정적 요소로 작용할 전망이다.
LG화학, 미 국책연구소와 협력
통해 글로벌 시장 진출 준비
최근 LG화학은 미국의 국책연구소인 A연구소와 조만간 차세대 2차전지 소재 개발을 위한 연구협력을 할 것으로 밝혔다.
LG화학은 협력을 통해 차세대 전지 개발과 이 분야에서의 글로벌 시장 진출 확대를 준비 중이다. LG화학은 이번 연구협력을 통해 미국의 원천기술을 공유하고 성능과 가격 경쟁력에서 앞선 전지 개발에 나설 수 있을 것으로 보고, 여기에 A연구소의 다수의 전기차용 리튬이온 2차 전지 특허를 통해 특허에 대한 공포에서 다소 자유로워질 수 있다고 기대하고 있다.
MOU를 교환하면 LG화학은 향후 미국 시장 진출의 속도를 높일 것으로 예상된다.
식약청, 나노 입자 크기 분석법 개발 식약청 식품의약품안전평가원(원자 김승희)은 나노물질 입자크기를 정밀하게 분석할 수 있는 시험법을 개발했다고 지난달 3일 밝혔다.
식약청 식품의약품안전평가원(원자 김승희)은 나노물질 입자크기를 정밀하게 분석할 수 있는 시험법을 개발했다고 지난달 3일 밝혔다.
개발된 시험법은 ▲나노제품의 원료가 되는 나노입자의 크기를 분석하기 위한 시험물질의 최소 입자수 ▲전처리 과정 및 입자의 평균크기 산출방법 등 기술 ▲전자현미경을 사용하는 나노입자 크기 분석의 정확성을 높이기 위하여 측정값의 분포 불확도를 산출하는 방법 개발 등이다.
현재 나노입자는 제약분야에서는 약물전달, 생체 이용률 향상, 특정 장기 표적 의약품 개발 등에 사용되며, 의료기기 분야에서는 진단, 질병 진단 도구의 개발에 활용되고 있으며, 전 세계적으로 2015년까지 약 1조 달러에 이를 것으로 예측되고 있다. 이번 시험법은 한국표준과학연구원(원장 김명수)과 공동연구를 통해 관련분야의 국제적 권위가 있는 학술지[Metrologia 46 1-9, (2009)]에 게재됨으로써 과학적 타당성을 인정받았다.
디지텍시스템스, L&D Korea 2010에서 다양한 터치스크린 소개
터치스크린 모듈업체인 디지텍시스템스(Digitech Systems)는 지난 달 2일부터 4일까지 대구 엑스코(EXCO)에서 열리는 ‘국제 라이팅&디스플레이코리아(L&D Korea 2010)’에서 다양한 터치스크린을 선보였다.
달 2일부터 4일까지 대구 엑스코(EXCO)에서 열리는 ‘국제 라이팅&디스플레이코리아(L&D Korea 2010)’에서 다양한 터치스크린을 선보였다.
디지텍시스템스의 터치스크린은 정전 용량방식과 저항막 방식이 있으며 지난 8월, 월 80만대 수준의 생산 규모를 구축했으며 내년까지 월 200만대로 확대할 계획이다.
디지텍시스템스는 저가형 소재인 소다라임글래스를 고급형 제품인 고릴라 글래스 수준으로 성능을 향상시켜 상당한 수준의 원가 절감에 성공했다. 코닝의 독점 제품인 고릴라 글래스는 강도 및 유연성에서 높은 품질을 보여 비싼 가격에도 불구하고 대부분의 터치 업체들이 이 제품을 적용해왔다. 디지텍시스템스는 소다라임 글래스에 특수처리 공정을 진행해 강도 및 유연성을 높였다. 묻어남 방지 기술인 지문방지(AF) 코팅도 기존 스퍼터링 방식이 아닌 스프레이 방식을 적용해 공정비용을 절감했다. 현재 삼성전자와 국내 거의 모든 내비게이션 업체들에 터치스크린을 납품하고 있다.
지이테크, 수질오염분야에
새로운 솔루션 제시 지난달 1일부터 4일까지 부산 벡스코(BEXCO)에서 열린 ‘국제 환경·에너지산업전(ENTECH 2010)’에서 지이테크(대표 조윤현)는 폐수처리용 다공성 폴리우레탄폼을 소개했다.
지난달 1일부터 4일까지 부산 벡스코(BEXCO)에서 열린 ‘국제 환경·에너지산업전(ENTECH 2010)’에서 지이테크(대표 조윤현)는 폐수처리용 다공성 폴리우레탄폼을 소개했다.
최근 공장에서 발생하는 산업폐수 처리는 지정된 환경법 규정을 만족시키는 폐수를 내보내야 하는 실정이다. 따라서 단독 폐수처리 시설의 필요성이 대두되고 있다.
대기수질분야 환경기술전문기업인 지이테크는 폐수처리용 다공성 폴리우레탄을 개발해 수질오염분야에 새로운 솔루션을 제시하고 있다.
지이테크가 소개하는 수처리 방식은 ‘유메디아 생물막 공법(Moving Bed Bio-Reactor, 이하 MBBR)’으로, 물에 미생물들이 활동할 수 있는 담체를 넣어 정화시키는 생물학적 방식이다. 담체로 이용되는 다공성 폴리우레탄을 폐수의 종류(식품 폐수, 염색 폐수)와 손상에 따라 5~20%까지 첨가한다.
지이테크의 유메디아 생물막 공법은 일반 담체에 비해 폐수에 따라 맞춤으로 담체를 설비할 수 있는 것이 장점이다.
목포 중심으로 세라믹산업 부상
지난달 18일 목포시는 지난해 10월 삽진일반산업단지 인근에 문을 연 ‘세라믹산업 종합지원센터’를 시작으로 생산 지원동과 인근에 세라믹일반산단이 조성되는 등 전남 목포시가 세라믹 산업의 거점도시로 부상하고 있다고 밝혔다.
세라믹지원센터는 전남도 신성장 동력산업의 하나로 지정된 신소재산업의 메카로 자동차, 반도체, 우주항공 등에 사용되는 부품 소재를 연구하고 개발하는 기업을 지원하고 있으며, 국내 유일의 비산화물 세라믹부품 산업화지원센터로 내년까지 총 300억원의 사업비를 투입해 기업성장 보육사업, 공동기술개발사업, 제품 시험제작 지원사업 등 다양한 기업지원사업을 펼 예정이다. 이뿐만 아니라 입주기업에 직접 제품을 생산할 수 있게 지원해주는 ‘생산지원동’을 건립하고 있으며 ‘고기능 원료 기반 구축사업’을 통해 수입에 의존하는 세라믹 원료를 자체 생산할 수 있는 기반도 마련할 계획이다.
세라믹센터 인근에 12만 3천㎡ 규모의 세라믹일반산단이 조성되면 국내외 세라믹부품제조업체가 입주해 명실상부한 세라믹 거점도시로 거듭나게 될 것으로 기대된다.
세라믹센터 기업 입주동에는 LG이노텍을 비롯해 12개 국내 유망 세라믹 기업들이 입주해 활발한 활동을 펼치고 있으며 오는 11월 추가로 5개 기업이 입주할 예정이다.
KCI, 에테르화 반응용 금속산화물 촉매 특허 획득
KCI는 지난달 2일 에테르화 반응용 금속산화물 촉매와 촉매 제조방법 및 촉매를 이용한 선형 폴리글리세롤의 제조방법에 대한 특허권을 취득했다고 공시했다.
삼정P&A-KC 합작사업 추진
포스코 계열 삼정P&A는 LED(발광다이오드) 발광칩을 만드는 데 쓰이는 사파이어 단결정의 원천 소재인 초고순도 알루미나(4N 99.99% 이상) 기술을 확보하기 위해 KC와 협력하는 내용의 양해각서를 체결했다고 지난달 9일 밝혔다.
KC는 알루미늄 원광석인 보크사이트에서 수산화 알루미나를 생산하는 국내 유일의 기업으로, 종전까지는 고순도(3N. 99.9%) 알루미나만을 생산해 왔다.
삼정P&A는 아번 양해각서 체결에 따라 3N 알루미나보다 한 단계 높은 4N 알루미나를 개발할 계획이다. 삼정 P&A는 4N 알루미나 추출 기술을 확보하게 되면 이를 바탕으로 사파이어 잉곳 사업에 진출할 계획이다.
LED의 원천소재인 사파이어 잉곳은 고순도 알루미나를 녹여 제작된다. 그동안 국내에서는 주로 일본의 쓰미토모 등에서 100% 수입해왔다.
포스코그룹 측은 “LED용 사파이어 단결정 세계시장 규모는 앞으로 10년내 2조 4000억원 규모로 커질 것으로 보고 있기 때문에 이번 사업 진출은 의미가 있다”고 덧붙였다.
이에 앞서 포스코와 포스코ICT는 서울반도체와 LED 조명 합작사를 설립키로 합의하는 등 LED사업을 신 수종 사업으로 추진해왔다.
삼정P&A는 철강제품에 대한 포장사업과 제강용 알루미늄 탈산제, 몰리브덴 등 철강원료판매등의 사업을 진행해왔으며 지난 상반기 매출액은 2559억원에 이른다.
미국엔 SCI, 한국엔 KCI
최근 한국연구재단은 올해 하반기 서비스 시작을 목표로 KCI(한국학술지인용색인·Korea Citation Index)라는 한국판 SCI를 개발하고 있다 밝혔다.
국내에는 지난 8월 말 한국연구재단 등록 기준으로 2635개의 학회와 1800여종에 이르는 학술지가 존재한다.
국내 학술지 등에 대한 재심사를 시작한 1998년에 56종에 그친 것과 비교하면 30배 이상이나 늘어난 것이다.
실제로 국내 연구수준을 끌어올리는 데 학회는 적지 않은 기여를 했다. 하지만 양만 많아져 연구수준이 떨어지는 학회가 양산되면서 국내 연구 전반의 신뢰를 떨어뜨리고 있다는 비판의 목소리도 높다.
학계는 국내 학회의 난립을 막고 자연스러운 학회 간 통합과 연계를 유도하기 위해서는 SCI 같은 객관적인 학술지 평가 시스템이 필요하다고 입을 모은다.
SCI는 미국의 톰슨로이터사가 개발한 과학기술논문인용색인이다. SCI에서 학술지를 검색하면 해당 학술지의 영향력 지수인 피인용지수(Impact Factor)가 함께 뜬다. 지수가 높으면 그만큼 다른 논문에서 인용이 많이 된 영향력 있는 논문이라는 뜻이다.
이번에 개발되는 KCI는 국내 학술지의 인용지수를 활용한 학술지 평가 시스템이다. 학술지와 게재된 논문 정보뿐만 아니라 SCI처럼 학술지와 논문의 피인용 횟수를 산출한 IF가 함께 제시된다. 또한 KCI에 등재된 학술지에 대해 3년에 한 번씩 주기적인 학술지 평가도 할 계획이다.
학계에서는 이번 KCI개발을 통해 경쟁력이 없는 학회 및 학술지의 난립 문제가 자연스럽게 해결될 수 있을 것으로 기대하고 있다.
지경부,
산업융합촉진법 제정안 의결
지난달 20일 지식경제부는 국무회의에서 산업융합촉진법 제정안이 심의·의결됐다고 밝혔다.
산업융합촉진법은 산업융합 시대로의 패러다임 전환에 대비하고, 산업융합을 통한 신성장동력을 육성하기 위한 지원체계이다.
산업융합촉진법이 제정됨에 따라 융합 신산업 관련 인력양성 및 교류, 표준화, 사업모델 개발, 보급지원, 국제협력, 정부출연 및 융자 등 지원에 대한 제도적 지원이 이뤄지게 됐다.
또 기준·규격·요건 등이 없어 제품출시가 지연된 융합 신제품에 대해 ‘패스트트랙(신속지원제도)’을 통한 인증·인허가를 허용, 신속한 시장출시가 가능토록 제도적으로 보완했다.
아울러 중소·중견기업을 대상으로 융합 신제품 개발지원 규정을 마련하고, ‘산업융합지원센터’를 활용해 민간전문가·연구장비·컨설팅 등을 지원할 계획이다. 특히 ‘산업융합촉진 옴부즈만’을 지정해 융합관련 기업애로를 수시로 발굴·해결한다는 방침이다.
이와 함께 산업융합정책을 총괄할 범부처 산업융합발전위원회를 설치하고, 산업융합특성화 대학원과 학부 융합학과 설치 및 지원근거를 마련했다.
지경부 관계자는 “산업융합촉진법 제정은 수십년간 산업발전법을 토대로 한 칸막이식 업종별 산업발전 패러다임 한계를 보완하는 계기를 마련한 면에서 큰 의미가 있다”고 말했다.
지경부, 원전계측제어시스템 개발
지식경제부는 지난달 16일 원전 미자립 3대 핵심 기술로 불리는 원전계측제어시스템(MMIS) 개발에 성공했다고 밝혔다.
지경부가 이번에 개발한 MMIS는 원전의 두뇌, 신경망 역할을 하는 것으로, 운전·제어·감시·계측 및 비상시 안전기능 등을 통합 관리하는 시스템이다.
또한 MMIS는 설계 단계부터 국산 제어기(PLC·Programmable Logic Controller)를 사용하고, 해외 MMIS에 비해 안전성, 신뢰성 및 운전 편의성이 뛰어난 것으로 평가받고 있다.
특히 원전의 노형이나 용량에 상관없이 국내·외 신규 및 가동원전에 활용할 수 있어 항공, 우주, 방위산업 등 다양한 분야의 안전 필수 제어기반 기술로도 활용이 가능할 것으로 지경부는 보고 있다.
MMIS 기술은 지경부와 교과부가 원자력 연구개발(R&D) 협력을 통해 개발에 성공했다. 지난 2001년부터 3단계에 걸쳐 총 863억원(정부 598억원, 민간 265억원)의 사업비가 투입됐다.
기사를 사용하실 때는 아래 고유 링크 주소를 출처로 사용해주세요.
https://www.cerazine.net